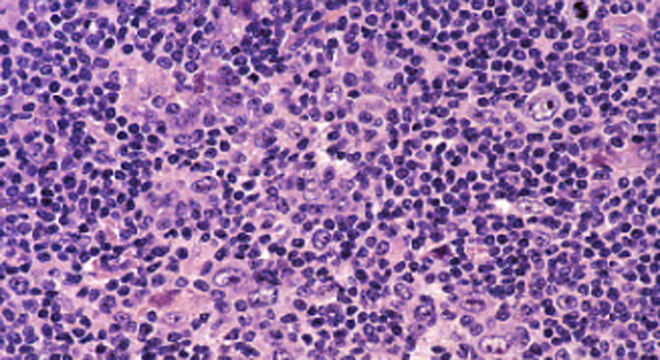

Beim Lymphom handelt es sich um einen Oberbegriff für Krebs erkrankungen des lymphatischen Systems (Lymphdrüsen-Krebs). Aufgepasst: Manchmal spricht der Mediziner auch von Lymphomen, wenn die Lymphknoten durch Infektionen vergrössert sind.
Das lymphatische System ist Teil des Immunsystems des Menschen. Es besteht aus einem komplexen Netzwerk lymphatischer Organe: Dazu gehören das Knochenmark, die Tonsillen (Mandeln), die Thymusdrüse (liegt hinter dem Brustbein), das lymphatische Gewebe mit sämtlichen Lymphknoten und die Milz.
Das maligne - bösartige - Lymphom tritt primär meist innerhalb des lymphatischen Gewebes von Lymphknoten auf und breitet sich über die Lymphbahnen aus. Die Lymphe (Flüssigkeit in den Lymphgefässen) ist verantwortlich für den Transport von Nährstoffen und Abfallprodukten.
Man unterscheidet zwei Hauptarten von Lymphomen (Lymphdrüsenkrebs):
- Hodgkin-Lymphom (Morbus Hodgkin) und
- Non-Hodgkin-Lymphome
Hodgkin-Lymphom (Morbus Hodgkin)
Der Morbus Hodgkin gehört zur Gruppe der malignen (bösartigen) Lymphome und wird durch bestimmte Riesenzellen (Sternberg-Reed Zellen) charakterisiert. Diese sterben nicht wie normale Lymphozyten ab, sondern produzieren immer mehr solche abnorme Zellen. Die Krankheit wurde 1832 vom Pathologen Thomas Hodgkin beschrieben, daher der Name. Die Prognosen sind insgesamt relativ gut.
Non-Hodgkin-Lymphome (NHL)
Die Non-Hodgkin-Lymphome, kurz als NHL bezeichnet, gehören wie der Morbus Hodgkin zur Gruppe der malignen (bösartigen) Lymphome. Im Gegensatz zum Morbus Hodgkin sind unter dem Begriff der NHL eine Vielzahl verschiedener bösartiger Lymphome zusammengefasst.
Dabei unterscheidet man zwischen niedrig-malignen und hoch-malignen Lymphomen.
Beim niedrig-malignen Lymphom teilen und vermehren sich die Tumorzellen langsam. Beim agressiven (hoch-malignen Lymphom) teilen und vermehren sich die Tumorzellen sehr rasch im Körper.
Niedrig maligne Lymphome können über Jahre bestehen und belasten den Patienten am Anfang der Erkrankung nicht allzu stark (schlimmer sind die Nebenwirkungen der Chemotherapien).
Die hoch-malignen Lymphome führen ohne Behandlung innerhalb von ein paar Monaten zum Tod. Bei frühzeitig angesetzter Therapie sind aber auch hier die Prognosen günstig.
Am häufigsten ist die Erkrankung bei den 20- bis 40-Jährigen und den über 70-Jährigen. Männer sind etwas öfter betroffen als Frauen. Weltweit sterben jährlich etwa 25'000 Menschen an dieser Erkrankung.